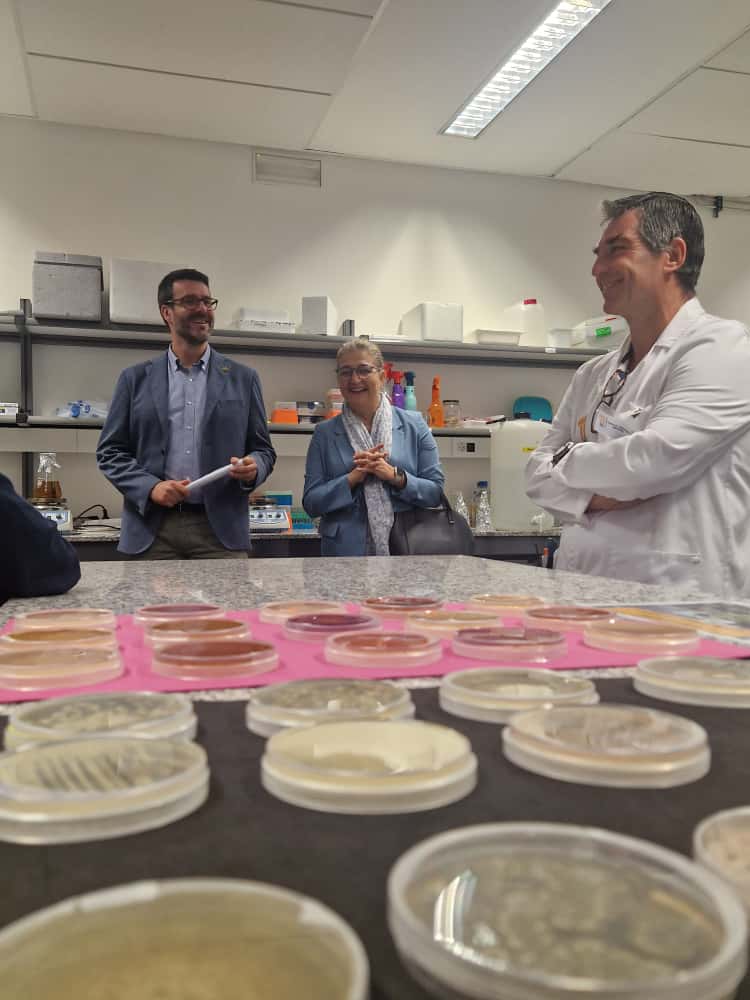
Programa Desayuna con la Ciencia+Cultura Emprendedora foto 5

20251107 Más de mil de alumnos de Primaria participarán este curso en el Programa Desayuna con la Ciencia+Cultura Emprendedora - Juntaex.es
20251107 Más de mil de alumnos de Primaria participarán este curso en el Programa Desayuna con la Ciencia+Cultura Emprendedora - Juntaex.es
Más de mil de alumnos de Primaria participarán este curso en el Programa Desayuna con la Ciencia+Cultura Emprendedora

Más de mil alumnos de 24 centros de Primaria de 19 localidades de la región participarán este curso en el Programa Desayuna con la Ciencia+Cultura Emprendedora para tomar contacto con la ciencia, la innovación y el emprendimiento, para que se interesen por el estudio, la investigación y la innovación, y para fomentar aptitudes científicas y tecnológicas. El programa ha comenzado este viernes en los Institutos Universitarios de Investigación del Campus de Badajoz, con la participación del alumnado del Colegio FEC San José de Villanueva de la Serena. Estas actividad se desarrollará hasta el próximo mes abril en el Campus de Cáceres y en los Centros Universitarios de Plasencia y Mérida, mientras que en el Campus de Badajoz el programa finalizará en mayo. La dinámica de Desayuna con la Ciencia+Cultura Emprendedora contempla un desayuno saludable en el que participan estudiantes e investigadores de los Institutos Universitarios de Investigación, y talleres prácticos y divertidos que implican observación, experimentación, reflexión y diálogo con esos investigadores. El programa está liderado por el Servicio de Difusión de la Cultura Científica (SDCC) en colaboración con Cultura Emprendedora Universidad de la Junta de Extremadura, y lleva desarrollándose desde el año 2012. La directora general de Universidad, Esther Muñoz Baquero, que ha asistido junto al vicerrector de Investigación y Trasferencia de la Uex, José María Carvajal González, a la inauguración de esta nueva edición, ha subrayado la continuidad del apoyo institucional a esta actividad. En este sentido, ha señalado que "la Junta de Extremadura sigue apoyando este programa, con el que tratamos de acercar a los estudiantes a la Universidad de Extremadura para despertar en ellos su curiosidad científica e innovadora, y para potenciar las habilidades emprendedoras que consideramos fundamentales en todos los ámbitos educativos". Por su parte, José María Carvajal ha destacado la importancia de esta iniciativa dentro de las acciones de divulgación y transferencia del conocimiento que impulsa la UEx y ha explicado que "este programa se enmarca en las actividades de difusión del Servicio de Cultura Científica, en el marco de la transferencia del conocimiento a la sociedad". Ha comentado que este programa "promueve incentivar y fomentar vocaciones científicas en nuestra cantera desde 5º y 6º de Primaria" y que es fundamental que el alumnado se acerque a la universidad desde tan joven, "para conocer a nuestros científicos, los institutos de investigación, los laboratorios y las facultades".